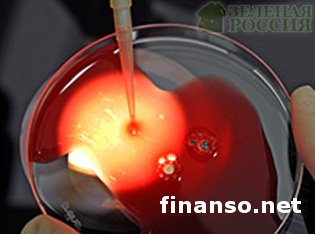

Ученым удалось создать искусственную кровь – выводыКатегория: Технологии
В ходе медиа-исследований из стволовых клеток человека была создана искусственная кровь, которая впервые в истории опробована (в рамках сенсационных исследований) на живых пациентах, о чем информируют корреспонденты издания «Украина сегодня: Finanso.net». В ходе медиа-исследований из стволовых клеток человека была создана искусственная кровь, которая впервые в истории опробована (в рамках сенсационных исследований) на живых пациентах, о чем информируют корреспонденты издания «Украина сегодня: Finanso.net».Запланированное на 2016 г. исследование, сможет, как считают ученые, заменить донорскую кровь, приступив к ее производству, возможно, даже в промышленных масштабах. О том, что их методика производства подойдет для изготовления красных кровяных телец в промышленных объемах сообщили шотландские ученые из Эдинбургского университета. Исследовательская группа доктора М. Тернера из индуцированных плюрипотентных стволовых клеток (перепрoграммированных в стволовые, зрелых клеток ткани, IPS), из которых сумели получить эритроциты. Учеными в ходе проводимого эксперимента, были выращены совместимые эритроциты, относящиеся к нулевой или первой группе крови. В ближайшее время М. Тернер с коллегами планирует приступить к клиническим испытаниям генно-инженерной крови. Получат ее первыми несколько пациентов с талассемией, тяжелым и редким заболеванием, требующим регулярного переливания крови. Кровь через время смогут производить в промышленных масштабах.На проведение этого исследования было выделено пять миллионов евро, и, как пояснил профессор М. Тернер, их исследовательская группа стала первой, получившей качественную искусственную кровь, которая соответствует всем необходимым стандартам для переливания крови. В промышленных масштабах, по мнению исследователей, в случае успешных опытов такая кровь будет производиться примерно через двадцать лет. По мнению российского ученого-генетика С. Киселева (Институт общей генетики РАН), если ученым удалось так продвинуться в исследованиях, то это по-настоящему значительный успех. Эти разработки ожидает большая перспектива, поскольку искусственная кровь может заменить со временем доноров. При европейских нормах в двадцать шесть-двадцать семь доноров на тысячу человек этот показатель в России вдвое меньше, не учитывая инфекции. Все начинается с небольшой пробирки, поэтому у исследователей впереди еще много испытаний, пока результат будет доведен до промышленных масштабов. Российские ученые на изучение этого же вопроса потратили около пяти лет, но для клинических испытаний требуется организация производства и соответствующее финансирование, которого у нас пока нет, о чем рассказал российский ученый. |
Автор: Виктор Кухтицкий
Уважаемый посетитель, Вы зашли на сайт как незарегистрированный пользователь. Мы рекомендуем Вам зарегистрироваться либо зайти на сайт под своим именем.



